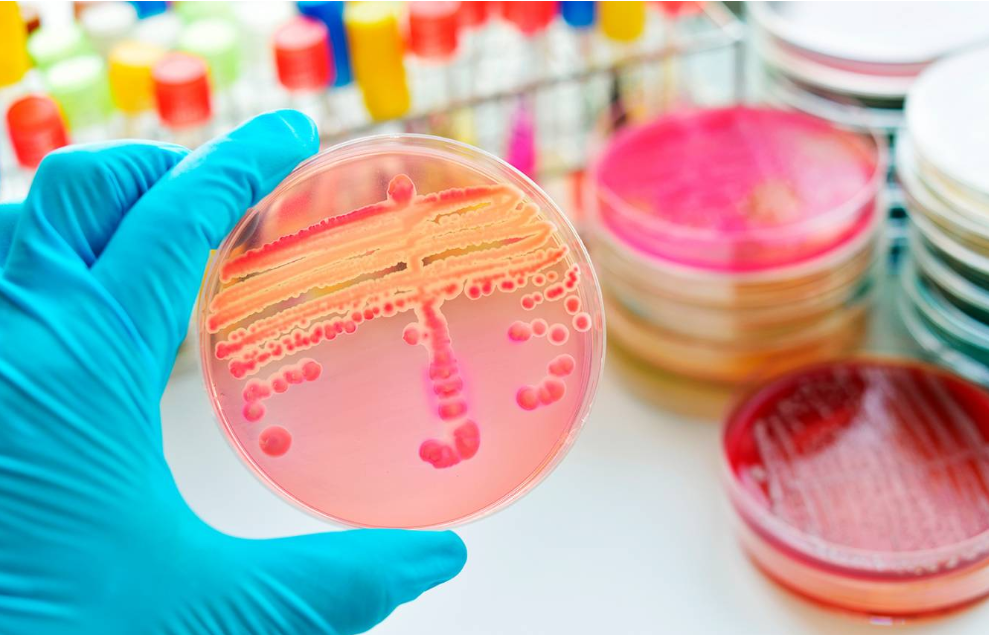

/Fuente: Federación Bioquímica de la Provincia de Buenos Aires /
Este año el Programa de Control de Alimentos –Procal– de la FBA incorpora cinco nuevos cursos a sus habituales actividades de capacitación, que estarán a cargo de reconocidos especialistas.
Se trata de los siguientes cursos: Microbiología de superficies vivas e inertes. Control Microbiológico de Ambientes en laboratorios de Microbiología. Control de ATP-Bioluminiscencia y Biofilms. Control de uso y limpieza de autoclaves. Aspectos generales de Legislación Alimentaria. Rótulo nutricional, RNE, RNPA.
MARZO 2026
Microbiología de Alimentos. Dr. Oscar López
Análisis Fisicoquímico de Aguas. Magíster Andrés Pighin
Inspectores Bromatológicos. Dr.Héctor Pittaluga
ABRIL 2026
Microbiología de Superficies vivas, inertes y aire en el ambiente de la Industria de Alimentos. Bióloga. Alina del Mar Infante.
Microbiología Aplicada al Control Bromatológico. Dr. Héctor Pittaluga.
MAYO 2026
Control Microbiológico de Aguas. Dr. Oscar López
Control Microbiológico de Ambientes en laboratorios de Microbiología. Bióloga Alina del Mar Infante
Implementación de Buenas Prácticas de Manufactura y POES. Lic. Silvana Di Pardo y Dr. Héctor Pittaluga
JUNIO 2026
Implementación de Sistema de Aseguramiento de la Calidad, HACCP. Dr. Héctor Pittaluga
Control de ATP-Bioluminiscencia y Biofilms en Industrias Alimenticias. Bióloga. Alina del Mar Infante
AGOSTO 2026
Inspectores Bromatológicos. Dr. Héctor Pittaluga
Calificación de Áreas limpias en Industria Alimentaria. Bióloga Alina del Mar Infante
SEPTIEMBRE 2026
Análisis Fisicoquímico de Aguas. Magíster Andrés Pighin
Control de uso y limpieza de autoclaves. Bióloga. Alina del Mar Infante
OCTUBRE 2026
Aspectos generales de Legislación Alimentaria. Rotulado de Alimentos. Registro de Establecimientos elaboradores y Productos alimenticios. Cátedra de Bromatología de la Facultad de Farmacia y Bioquímica. UBA. Titular Dra. Laura López
Microbiología de Ambientes en laboratorios de Microbiología según ISO 17025:2017
NOVIEMBRE 2026
Control Microbiológico de Aguas. Dr. Oscar López
Microbiología Aplicada al Control Bromatológico. Dr. Héctor Pittaluga
Para más información comunicarse a: procal@fba.org.ar